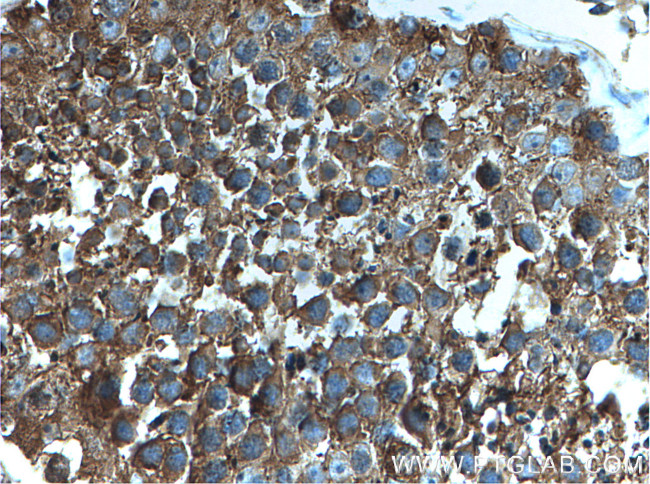
PRKACA Antibody in Immunohistochemistry (Paraffin) (IHC (P))

Search
Proteintech
PRKACA Polyclonal Antibody
{{$productOrderCtrl.translations['antibody.pdp.commerceCard.promotion.promotions']}}
{{$productOrderCtrl.translations['antibody.pdp.commerceCard.promotion.viewpromo']}}
{{$productOrderCtrl.translations['antibody.pdp.commerceCard.promotion.promocode']}}: {{promo.promoCode}} {{promo.promoTitle}} {{promo.promoDescription}}. {{$productOrderCtrl.translations['antibody.pdp.commerceCard.promotion.learnmore']}}








Please note: We are reviewing Western blot images included in the antibody testing data in our catalog, including those provided by third parties. Unless expressly labeled or annotated as “raw-unedited”, Western blot images included in the antibody testing data in our catalog may have been edited, optimized or otherwise adjusted for presentation.
Product Details
27398-1-AP
Species Reactivity
Host/Isotype
Class
Type
Immunogen
Conjugate
Form
Concentration
Amount
Purification
Storage buffer
Contains
Storage conditions
Shipping conditions
Product Specific Information
Immunogen sequence: DLIYRDLKP ENLLIDQQGY IQVTDFGFAK RVKGRTWTLC GTPEYLAPEI ILSKGYNKAV DWWALGVLIY EMAAGYPPFF ADQPIQIYEK IVSGKVRFPS HFSSDLKDLL RNLLQVDLTK RFGNLKNGVN DIKNHKWFAT TDWIAIYQRK VEAPFIPKFK GPGDTSNFDD YEEEEIRVSI NEKCGKEFSE F (162-351 aa encoded by BC039846)
Target Information
Protein kinase A (PKA, cAMP-dependent protein kinase) is a key element of a ubiquitous signaling pathway important in the cell cycle, cellular communication, memory formation and behavior. PKA is composed of two catalytic (PKAc; Protein Kinase A catalytic subunit) and two regulatory subunits (PKAr). Upon binding cAMP, the complex dissociates to PKAr dimer and two activated PKAc ser/thr protein kinase catalytic monomers. The released PKAc can translocate into the nucleus and exert a regulatory role in the activation of multiple nuclear hormone receptors. However, PKAc-mediated activation of tonicity-dependent gene expression is cAMP independent. Humans express three types of PKAc subunit - PKAc alpha is present in most human tissues, PKAc beta and gamma are tissue-specific, the later is found in testes.
For Research Use Only. Not for use in diagnostic procedures. Not for resale without express authorization.
Bioinformatics
Protein Aliases: C(s); C-alpha-2; C-alpha-S; cAMP-dependent protein kinase catalytic subunit alpha; MGC102831; MGC48865; PKA; PKA C-alpha; pkac
Gene Aliases: PKACA; PRKACA
Entrez Gene ID: (Human) 5566

Performance Guarantee
If an Invitrogen™ antibody doesn't perform as described on our website or datasheet,we'll replace the product at no cost to you, or provide you with a credit for a future purchase.*
Learn more
We're here to help
Get expert recommendations for common problems or connect directly with an on staff expert for technical assistance related to applications, equipment and general product use.
Contact tech support